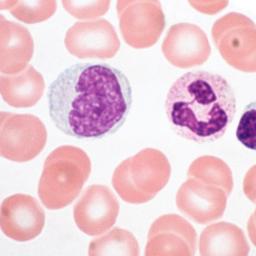
Story Image

External Content
| Source | RSS or Atom Feed |
| Feed Location | http://www.nrc.nl/rss.php |
| Feed Title | Nieuws, achtergronden en onderzoeksjournalistiek - NRC |
| Feed Link | https://www.nrc.nl/ |
| Feed Copyright | Mediahuis NRC BV, Amsterdam. Deze RSS-feed is uitsluitend bedoeld voor persoonlijk, niet-commercieel gebruik. Op ieder gebruik van RSS-feeds van NRC zijn de Leveringsvoorwaarden van toepassing: https: |
| Reply | 0 comments |